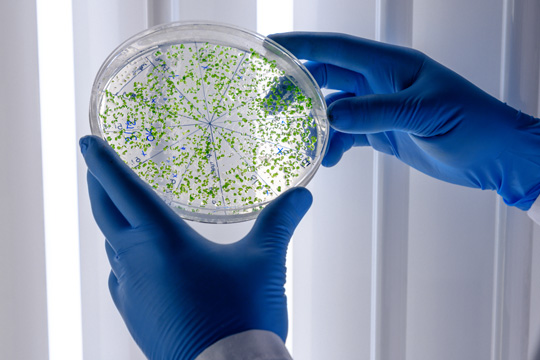
Embark on a Journey of Discovery

PHYSICAL & BIOLOGICAL SCIENCES
From Anatomy to Zoology and Everything in Between—Trusted Texts in the Physical & Biological Sciences
Browse by Subject
Comprehensive
Providing learners with comprehensive resources that help them succeed, including assessments, learning materials and study guides.
Career-Focused
Our texts and resources help learners prepare for their future professions with real-world applications and activities.
Authoritative
Our experienced authors are subject matter experts with extensive knowledge and expertise in their fields.

Must-have for the
Introductory
Botany Course
Setting the standard for learning the fundamentals of plant science!
Learn More
Best-Selling
Provides learners with the fundamentals of genetics from the genomics perspective.
Learn More
Best-Selling
Introduces students to the key concepts from geology, chemistry, physics, and biology as they relate to ocean environments.
Learn More
Student-Friendly
Building a solid conceptual framework of Cell Biology using 14 easy-to-understand principles.
Learn More
Jeff Pommerville’s
Best-Seller in
Microbiology!
The ideal Introductory Text for Students in Health Professions
Learn More


Have a Look at Some of Our Market-Leading
Physical & Biological Science Educational Resources
Embark on a Journey of Discovery with Our Collection of Physical and Biological Science Textbooks and Learning Materials!
In the ever-evolving landscape of scientific discovery, our collection of biological and physical science textbooks stands as a trusted collection of resources, offering an enriching and immersive content by experts in the field. Whether you're a student venturing into the fascinating realms of biology and physics or a seasoned professional seeking to deepen your understanding, our curated materials are designed to ignite curiosity, foster critical thinking, and propel you toward academic and career excellence.

Comprehensive Content for Holistic Learning:
Our textbooks go beyond the ordinary, providing comprehensive coverage of biological and physical science concepts. Each page is a gateway to exploration, featuring engaging narratives, vivid illustrations, and real-world applications that bring scientific theories to life. From the principles of cellular biology to the depths of environmental chemistry, our materials are a roadmap to understanding the fundamental principles that govern the natural world.
Versatility for Diverse Audiences:
Whether you are a high school student, undergraduate, graduate student, or a professional in the field, our materials are tailored to cater to diverse learning needs. Clear, accessible language and a progressive learning structure make our textbooks suitable for beginners and advanced learners alike. We believe that everyone should have the opportunity to unlock the wonders of science, and our materials provide the pathway to success at any level.


Practical Application and Problem-Solving Skills:
Science is not just about theory; it's about applying knowledge to solve real-world problems. Our learning materials emphasize practical application, providing exercises and case studies that challenge learners to think critically and develop problem-solving skills. Whether you're conducting experiments in a laboratory or tackling complex physics equations, our materials prepare you for the challenges of scientific inquiry and application.
Inspiring a Lifelong Love of Science:
Beyond examinations and professional pursuits, our textbooks are designed to instill a lifelong passion for science. By presenting the subject matter in an engaging and relatable manner, we aim to foster a love for exploration and discovery that extends far beyond the classroom. We believe that a genuine curiosity about the natural world is the driving force behind meaningful scientific contributions, and our materials are crafted to inspire the next generation of innovators and thought leaders.

